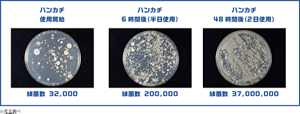
ハンカチ使用開始　細菌数 32,000　ハンカチ6時間後（半日使用）　細菌数 200,000　ハンカチ48時間後（2日使用）　細菌数 37,000,000　※花王調べ
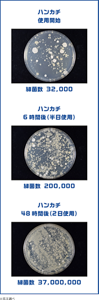
ハンカチ使用開始　細菌数 32,000　ハンカチ6時間後（半日使用）　細菌数 200,000　ハンカチ48時間後（2日使用）　細菌数 37,000,000　※花王調べ

- メンズビオレTOP
- 男の肌・ニオイ研究所
- こんなときに使える!ボディシート活用術



駅まで歩いたり、人ごみに入ったり、スポーツをしたり。日常には汗をかくシーンがたくさんあります。汗をかいたまま放っておくと、ニオイが気になりがち。だけど、外出先でシャワーは浴びられない・・・そんなときにおすすめなのが、ボディシートです。



例えば30代男性では、女性の約3倍の汗をかきます。
一般的にニオイは、汗が菌に反応して発生するもの。つまり、男性は女性よりも、ニオイが発生しやすい肌環境にあるのです。ニオイの原因となる汗はこまめにふきとることが大切です。




ハンカチやタオルで体をふく人もいるかもしれませんね?実は、汗をふいて湿ったハンカチは、雑菌の温床になりやすいといわれているのです。さらに、汗をふくだけでなく、手洗いのあとにも使うなど、1日何度も使うなかで、雑菌の繁殖は増える一方です。下記の実験では半日後になんと約6.25倍の細菌が増殖するという結果に!せっかく汗をふくのだから、清潔なハンカチでふきたいですね。 常にフレッシュに使えるボディシートがおすすめです。

- メンズビオレTOP
- 男の肌・ニオイ研究所
- こんなときに使える!ボディシート活用術




















